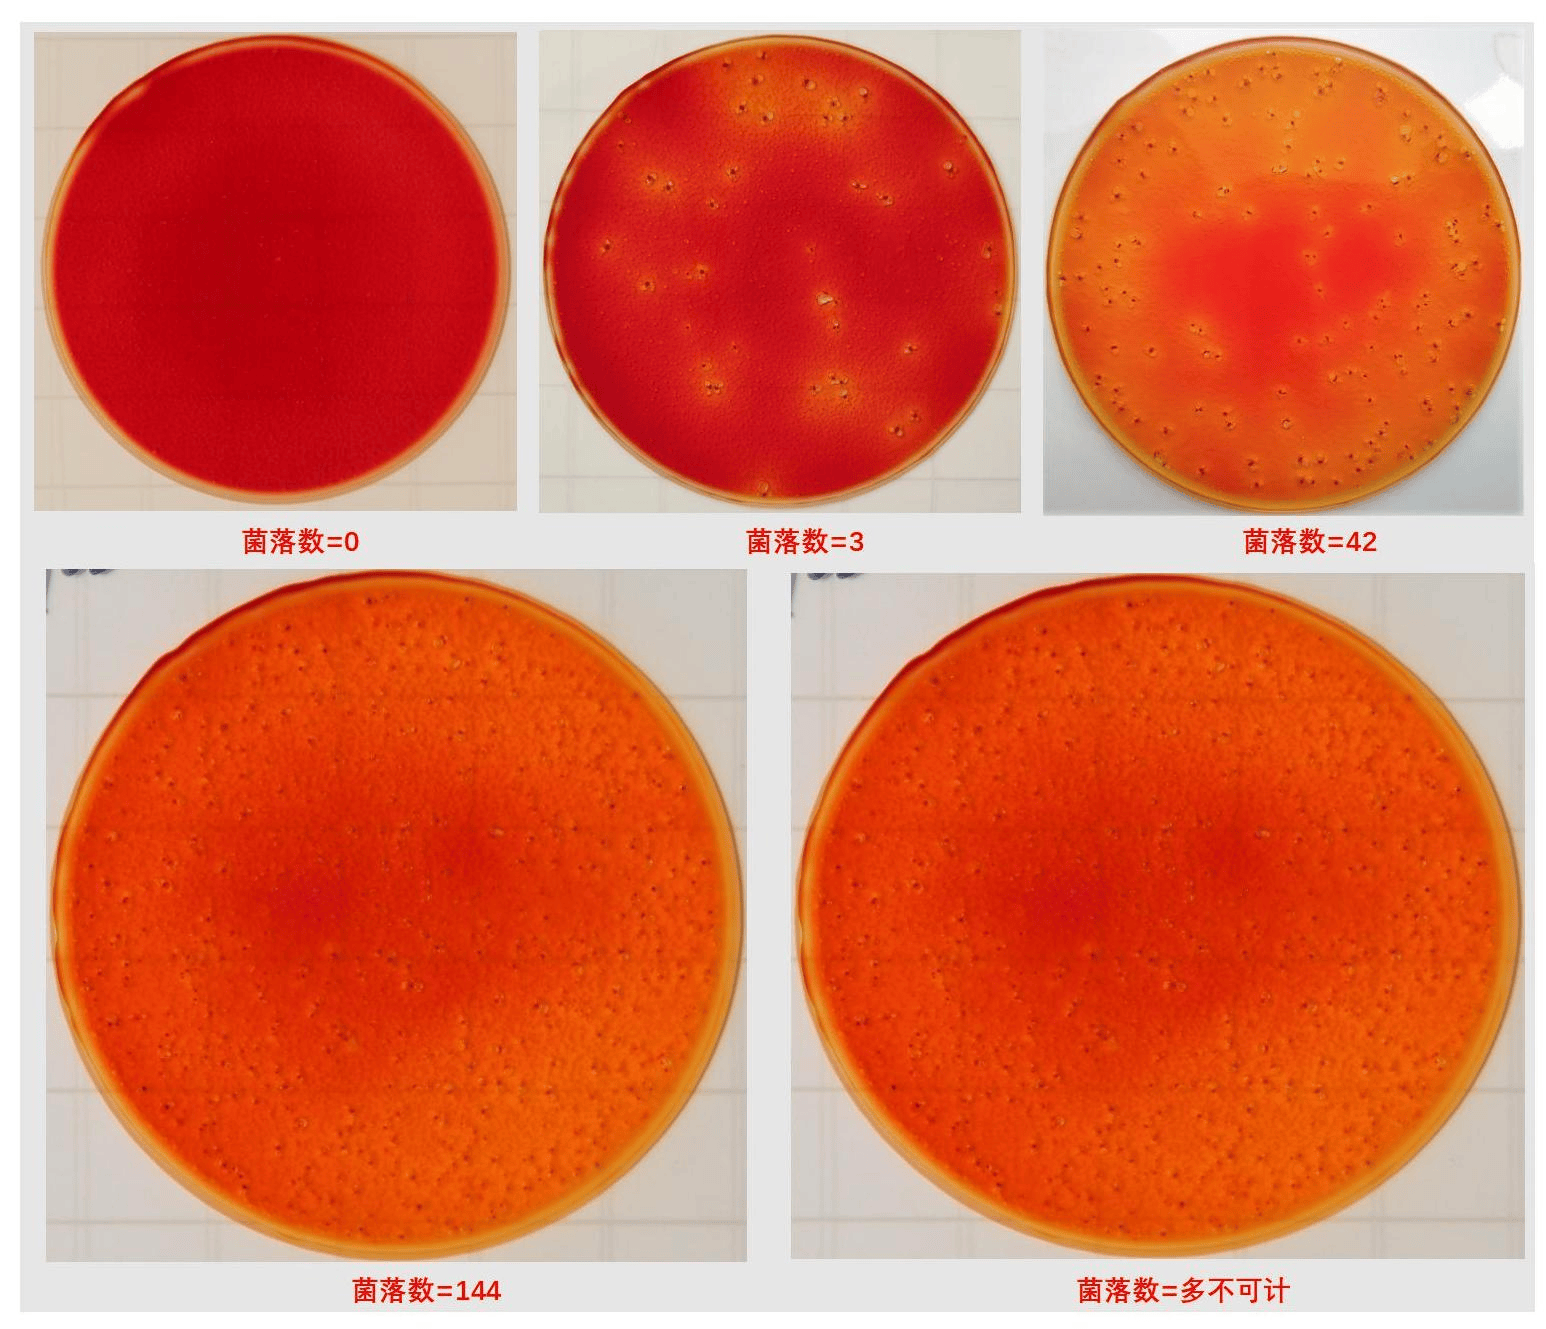
检测_样品_培养基

肠道菌群检测

肠道菌群检测 - 美嘉大健康商城
图片尺寸1500x2056
我的肠道菌群检测结果出来了
图片尺寸1700x2266
肠道菌群检测 - 美嘉大健康商城
图片尺寸1500x2348
肠道菌群检测 - 美嘉大健康商城
图片尺寸1500x2117
肠道菌群检测出来了!我的肠道竟然"老"了
图片尺寸2048x2724
肠道菌群检测 肠道菌群第三方检测机构
图片尺寸1242x1647
检测_样品_培养基
图片尺寸1546x1329
肠道菌群检测.肠道菌群检测的内容: 1:检测整个肠道微生态;
图片尺寸750x1262
为自己定一份肠道菌群检测
图片尺寸1061x1986
肠道菌群检测
图片尺寸1440x1080
肠道菌群基因测序
图片尺寸730x1261
肠道菌群检测仪器:解锁健康密码的科技利器
图片尺寸660x994
肠道菌群检测,低成本高效率在家就可以操作的绿色检测,从营养
图片尺寸1080x1806
肠道菌群检测
图片尺寸750x1200
肠道菌群检测你做了吗
图片尺寸1080x1438
肠道菌群基因检测:健康的新"导航仪"
图片尺寸1080x1410
肠道菌群检测,不出门就等报告#肠道菌群 #肠道菌群检测
图片尺寸1242x1660
肠道菌群检测,解读您的肠道"密语"
图片尺寸790x967
肠道菌群检测:健康的新守护者 💪
图片尺寸1389x687
肠道菌群活性检测
图片尺寸1080x1439